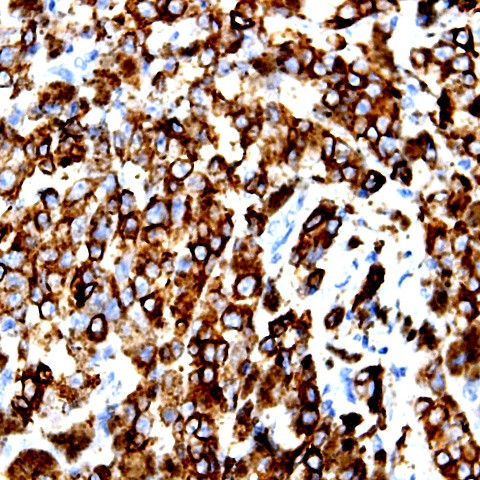
Phospho-BCAR3 (Thr130) Antibody in Immunohistochemistry (Paraffin) (IHC (P))

Search
AbboMax
Phospho-BCAR3 (Thr130) Polyclonal Antibody
{{$productOrderCtrl.translations['antibody.pdp.commerceCard.promotion.promotions']}}
{{$productOrderCtrl.translations['antibody.pdp.commerceCard.promotion.viewpromo']}}
{{$productOrderCtrl.translations['antibody.pdp.commerceCard.promotion.promocode']}}: {{promo.promoCode}} {{promo.promoTitle}} {{promo.promoDescription}}. {{$productOrderCtrl.translations['antibody.pdp.commerceCard.promotion.learnmore']}}
图: 1 / 2
Phospho-BCAR3 (Thr130) Antibody (600-080) in IHC (P)


产品信息
600-080
种属反应
宿主/亚型
分类
类型
抗原
偶联物
形式
浓度
纯化类型
保存液
内含物
保存条件
运输条件
产品详细信息
Positive control: Breast carcinoma
Cellular location: Cytoplasm.
靶标信息
Breast tumors are initially dependent on estrogens for growth and progression and can be inhibited by anti-estrogens such as tamoxifen. However, breast cancers progress to become anti-estrogen resistant. Breast cancer anti-estrogen resistance gene 3 was identified in the search for genes involved in the development of estrogen resistance. The gene encodes a component of intracellular signal transduction that causes estrogen-independent proliferation in human breast cancer cells. The protein contains a putative src homology 2 (SH2) domain, a hall mark of cellular tyrosine kinase signaling molecules, and is partly homologous to the cell division cycle protein CDC48.
仅用于科研。不用于诊断过程。未经明确授权不得转售。
篇参考文献 (0)
生物信息学
蛋白别名: BCAR3 adapter protein, NSP family member; Breast cancer anti-estrogen resistance protein 3; Breast cancer anti-estrogen resistance protein 3 homolog; breast cancer antiestrogen resistance 3 protein; dJ1033H22.2 (breast cancer anti-estrogen resistance 3); KIAA0554; Novel SH2-containing protein 2; OTTHUMP00000011961; p130Cas-binding protein AND-34; SH2 domain-containing protein 3B
基因别名: AI131758; AND-34; And34; BCAR3; NSP2; SH2D3B; UNQ271/PRO308
UniProt ID: (Human) O75815, (Mouse) Q9QZK2, (Rat) D3ZAZ5
Entrez Gene ID: (Human) 8412, (Mouse) 29815, (Rat) 310838